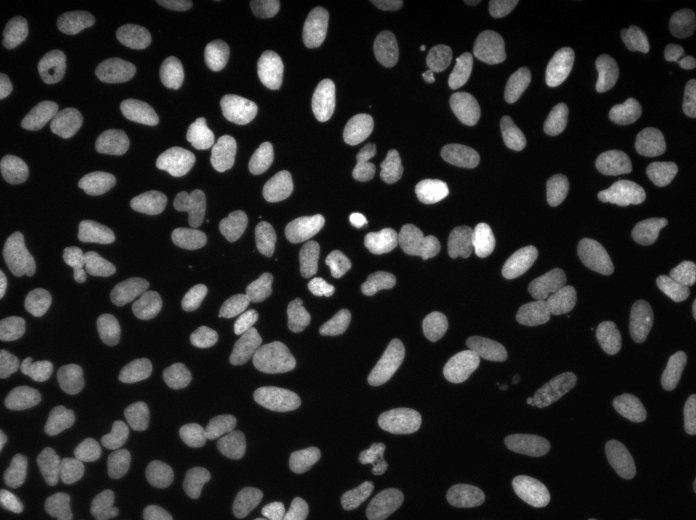

Pytorch-Implementierung von 3D-U-NET und seinen Varianten:
UNet3D Standard 3D-U-NET basierend auf 3D-U-NET: Lernen dichter volumetrischer Segmentierung aus sparsamer Annotation
ResidualUNet3D Residual 3D U-NET basierend auf übermenschlicher Genauigkeit auf der SNEMI3D Connectomics Challenge
ResidualUNetSE3D ähnlich wie bei ResidualUNet3D mit Zugabe von Quetschungs- und Anregungsblöcken auf der semantischen Segmentierung von Deep Learning für hochauflösende medizinische Volumina. Ursprünglich
Der Code ermöglicht das Training der U-NET für beide: semantische Segmentierung (Binär- und Mehrklassen) und Regressionsprobleme (z. B. De-Nr., Lernentwicklungen).
2D U-NET wird ebenfalls unterstützt, siehe 2Dunet_Confocal oder 2Dunet_DSB2018, beispielsweise Konfiguration. Stellen Sie einfach sicher, dass Sie das Singleton Z-Dimension in Ihrem H5-Datensatz (dh (1, Y, X) anstelle von (Y, X) ) aufbewahren, da die Datenbelastung / Datenvergrößerung Tensoren von Rang 3 erforderlich sind. Das 2D-U-NET selbst verwendet selbst die Standard-2D-Faltungsschichten anstelle von 3D-Konflikten mit Kerngröße (1, 3, 3) aus Leistungsgründen.
Die Eingabedaten sollten in HDF5 -Dateien gespeichert werden. Die HDF5 -Dateien für das Training sollten zwei Datensätze enthalten: raw und label . Optional sollte beim Training mit PixelWiseCrossEntropyLoss ein weight bereitgestellt werden. Der raw -Datensatz sollte die Eingabedaten enthalten, während der label die Bodenwahrheitsbezeichnungen. Der optionale weight sollte die Werte für die Gewichtung der Verlustfunktion in verschiedenen Regionen der Eingabe enthalten und von der gleichen Größe wie label haben. Das Format der raw / label hängt davon ab, ob das Problem 2D oder 3D ist und ob die Daten einkanal oder ein Mehrkanal-Mehrkanal sind, siehe die folgende Tabelle:
| 2d | 3d | |
|---|---|---|
| Einzelkanal | (1, y, x) | (Z, y, x) |
| Multi-Channel | (C, 1, y, x) | (C, Z, Y, X) |
pytorch-3dunet ist ein plattformübergreifendes Paket und wird auch unter Windows und OS X ausgeführt.
pytorch-3dunet -Paket zu installieren, ist über Conda/Mamba: conda install -c conda-forge mamba
mamba create -n pytorch-3dunet -c pytorch -c nvidia -c conda-forge pytorch pytorch-cuda=12.1 pytorch-3dunet
conda activate pytorch-3dunet
Nach der Installation sind die folgenden Befehle in der Conda -Umgebung zugänglich: train3dunet für das Training des Netzwerks und predict3dunet für die Vorhersage (siehe unten).
python setup.py install
Stellen Sie sicher, dass der installierte pytorch mit Ihrer CUDA -Version kompatibel ist, andernfalls wird das Training/die Vorhersage nicht auf GPU ausgeführt.
Angesichts der Tatsache, dass das pytorch-3dunet Paket wie oben beschrieben über Conda installiert wurde, kann man das Netzwerk trainieren, indem man einfach aufgerufen wird:
train3dunet --config <CONFIG>
wobei die CONFIG der Pfad zu einer YAML -Konfigurationsdatei ist, in der alle Aspekte des Trainingsvorgangs angegeben sind.
Um Ihre eigenen Daten zu trainieren, geben Sie einfach die Pfade zu Ihren HDF5 -Schulungs- und Validierungsdatensätzen in der Konfiguration.
Man kann den Trainingsfortschritt mit Tensorboard tensorboard --logdir <checkpoint_dir>/logs/ (Sie benötigen in Ihrem Conda Env installiert checkpoint_dir tensorflow Pfad zum in der Konfiguration angegebenen Checkpoint -Verzeichnis installiert ist.
BCEWithLogitsLoss , DiceLoss , BCEDiceLoss , GeneralizedDiceLoss : Die Zieldaten müssen 4D (eine Ziel-Binärmaske pro Kanal) sein. Beim Training mit WeightedCrossEntropyLoss , CrossEntropyLoss , PixelWiseCrossEntropyLoss muss der Zieldatensatz 3D sein, siehe auch Pytorch -Dokumentation für CE -Verlust: https://pytorch.org/docs/master/generated/torch.nn.crossentross.html.html.html.html.html.final_sigmoid im model gilt nur für die Inferenzzeit (Validierung, Test):BCEWithLogitsLoss , DiceLoss final_sigmoid=True BCEDiceLoss , GeneralizedDiceLoss setzenWeightedCrossEntropyLoss , CrossEntropyLoss , PixelWiseCrossEntropyLoss ) setzen Sie final_sigmoid=False , damit die Normalisierung Softmax -Normalisierung auf den Ausgang angewendet wird. Da das pytorch-3dunet -Paket wie oben beschrieben über Conda installiert wurde, kann die Vorhersage über:
predict3dunet --config <CONFIG>
Um Ihre eigenen Daten vorherzusagen, geben Sie einfach den Pfad für Ihr Modell sowie die Pfade zu HDF5 -Testdateien an (siehe Beispiel test_config_segmentation.yaml).
LazyHDF5Dataset und LazyPredictor in der Konfiguration verwenden. Dies spart Speicher, indem Daten auf Kosten einer langsameren Vorhersagezeit im laufenden Fliegen geladen werden. Eine Beispielkonfiguration finden Sie test_config_lazy.save_segmentation: true im predictor -Abschnitt der Konfiguration (siehe test_config_multiclass). Wenn mehrere GPUs verfügbar sind, werden im gesamten GPUs mithilfe von Dataparallel Training/Vorhersage verfügbar. Wenn das Training/die Vorhersage für alle verfügbaren GPUs nicht wünschenswert ist, beschränken Sie die Anzahl der GPUs mit CUDA_VISIBLE_DEVICES , z. B.
CUDA_VISIBLE_DEVICES=0,1 train3dunet --config < CONFIG >oder
CUDA_VISIBLE_DEVICES=0,1 predict3dunet --config < CONFIG > BCEWithLogitsLoss (Binärer Kreuzentropie)DiceLoss (Standard DiceLoss definiert als 1 - DiceCoefficient für binäre semantische Segmentierung verwendet; wenn mehr als 2 Klassen in der Grundwahrheit vorhanden sind, berechnet es den DiceLoss pro Kanal und durchschnittlich die Werte).BCEDiceLoss (Lineare Kombination aus BCE- und Würfelverlusten, dh alpha * BCE + beta * Dice , alpha, beta kann im loss der Konfiguration angegeben werden)CrossEntropyLoss (man kann Klassengewichte über das weight: [w_1, ..., w_k] im loss der Konfiguration)PixelWiseCrossEntropyLoss (man kann pro Pixelgewichte angeben, um den wichtigen/unterrepräsentierten Regionen in der Bodenwahrheit mehr Gradienten zu verleihen; weight muss in den H5-Dateien zur Schulung und Validierung bereitgestellt werden; siehe Beispielkonfiguration in train_config.ymlWeightedCrossEntropyLoss (siehe "Gewichtete Kreuzungstropie (WCE)" im folgenden Papier für eine detaillierte Erklärung)GeneralizedDiceLoss (siehe "Generalisierte Würfelverlust (GDL)" im folgenden Papier für eine detaillierte Erklärung) Hinweis: Verwenden Sie diese Verlustfunktion nur, wenn die Beschriftungen im Trainingsdatensatz sehr unausgeglichen sind, z. B. eine Klasse mit mindestens 3 Größenordnungen mehr Voxel als die anderen. Ansonsten verwenden Sie Standard DiceLoss .Eine detaillierte Erläuterung einiger der unterstützten Verlustfunktionen finden Sie unter: Verallgemeinerte Würfel überlappen sich als Deep -Learning -Verlustfunktion für hoch unausgeglichene Segmentierungen.
MSELoss (mittlerer quadratischer Fehlerverlust)L1Loss (mittlerer absoluter Fehlerverlust)SmoothL1Loss (weniger empfindlich gegenüber Ausreißern als Mseloss)WeightedSmoothL1Loss SmoothL1Loss MeanIoU (mittlere Kreuzung über Union)DiceCoefficient (berechnet pro Kanal Würfelkoeffizient und gibt den Durchschnitt zurück) Wenn ein 3D-U-NET geschult wurde, um Zellgrenzen vorherzusagen, kann man die folgenden Semantik-Instanz-Segmentierungsmetriken verwenden (die folgenden Metriken werden durch Ausführen verbundener Komponenten auf der Schwellengrenzkarte berechnet.BoundaryAveragePrecision (durchschnittliche Genauigkeit, die auf die Grenzwahrscheinlichkeitskarten angewendet wird: Schwellenwerte Die Ausgabe aus dem Netzwerk, führt verbundene Komponenten aus, um die Segmentierung zu erhalten, und berechnet AP zwischen der resultierenden Segmentierung und der Grundwahrheit)AdaptedRandError (siehe http://braineiac2.mit.edu/snemi3d/evaluation für eine detaillierte Erklärung)AveragePrecision (siehe https://www.kaggle.com/stkbailey/step-by-step- explanation-of-scoring-metric) Wenn nicht angegeben wird, wird MeanIoU standardmäßig verwendet.
PSNR (Peak -Signal -Rausch -Verhältnis)MSE (mittlerer quadratischer Fehler) Trainings-/Vorhersagenkonfigurationen finden Sie in 3Dunet_Lightsheet_Boundary. Vorausgebildete Modellgewichte hier verfügbar. Um das vorgebildete Modell für Ihre eigenen Daten zu verwenden:
best_checkpoint.pytorch Link herunterpredict3dunet --config test_config.ymlpre_trained Attribut in der YAML best_checkpoint.pytorch Konfiguration einstellenDie für das Training verwendeten Daten können aus dem folgenden OSF -Projekt heruntergeladen werden:
Probe Z-Slice-Vorhersagen im Testsatz (oben: RAW-Eingang, unten: Grenzvorhersagen):


Trainings-/Vorhersagenkonfigurationen finden Sie in 3Dunet_Confocal_Boundary. Vorausgebildete Modellgewichte hier verfügbar. Um das vorgebildete Modell für Ihre eigenen Daten zu verwenden:
best_checkpoint.pytorch Link herunterpredict3dunet --config test_config.ymlpre_trained Attribut in der YAML best_checkpoint.pytorch Konfiguration einstellenDie für das Training verwendeten Daten können aus dem folgenden OSF -Projekt heruntergeladen werden:
Probe Z-Slice-Vorhersagen im Testsatz (oben: RAW-Eingang, unten: Grenzvorhersagen):


Trainings-/Vorhersagenkonfigurationen finden Sie in 3Dunet_Lightsheet_nuclei. Vorausgebildete Modellgewichte hier verfügbar. Um das vorgebildete Modell für Ihre eigenen Daten zu verwenden:
best_checkpoint.pytorch Link herunterpredict3dunet --config test_config.ymlpre_trained Attribut in der YAML best_checkpoint.pytorch Konfiguration einstellenDie Schulungs- und Validierungssätze können aus dem folgenden OSF -Projekt heruntergeladen werden: https://osf.io/thxzn/
Probe Z-Slice-Vorhersagen auf dem Testsatz (oben: RAW-Eingang, unten: Kernevorhersagen):


Die Daten können heruntergeladen werden: https://www.kaggle.com/c/data-science-bowl-2018/data
Trainings-/Vorhersagenkonfigurationen finden Sie in 2Dunet_DSB2018.
Probenvorhersagen auf dem Testbild (oben: Roheingang, unten: Kernevorhersagen):

Wenn Sie zurückbeitragen möchten, stellen Sie bitte eine Pull -Anfrage.
Wenn Sie diesen Code für Ihre Forschung verwenden, zitieren Sie bitte:
@article {10.7554/eLife.57613,
article_type = {journal},
title = {Accurate and versatile 3D segmentation of plant tissues at cellular resolution},
author = {Wolny, Adrian and Cerrone, Lorenzo and Vijayan, Athul and Tofanelli, Rachele and Barro, Amaya Vilches and Louveaux, Marion and Wenzl, Christian and Strauss, Sören and Wilson-Sánchez, David and Lymbouridou, Rena and Steigleder, Susanne S and Pape, Constantin and Bailoni, Alberto and Duran-Nebreda, Salva and Bassel, George W and Lohmann, Jan U and Tsiantis, Miltos and Hamprecht, Fred A and Schneitz, Kay and Maizel, Alexis and Kreshuk, Anna},
editor = {Hardtke, Christian S and Bergmann, Dominique C and Bergmann, Dominique C and Graeff, Moritz},
volume = 9,
year = 2020,
month = {jul},
pub_date = {2020-07-29},
pages = {e57613},
citation = {eLife 2020;9:e57613},
doi = {10.7554/eLife.57613},
url = {https://doi.org/10.7554/eLife.57613},
keywords = {instance segmentation, cell segmentation, deep learning, image analysis},
journal = {eLife},
issn = {2050-084X},
publisher = {eLife Sciences Publications, Ltd},
}